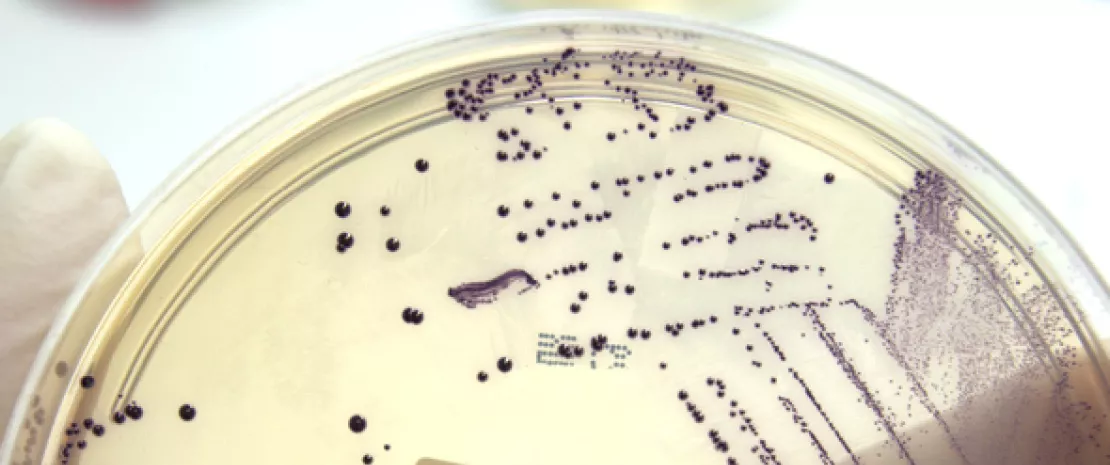
Photo : Lantibiotics: a new avenue in the fight against resistant bacteria

Лантибиотики: новый способ борьбы с резистентными бактериями
Колонизация желудочно-кишечного тракта ванкомицин-резистентным штаммом Enterococcus faecium может быть в значительной степени снижена за счет применения бактерий, которые естественным образом синтезируют эффективный и селективный лантибиотик*.
Раздел для широкой публики
Найдите здесь свое выделенное местоen_sources_title
en_sources_text_start en_sources_text_end
Делиться - значит заботиться
Возможно, эта тема заинтересует ваших коллег. Почему бы не поделиться ею?
Об этой статье
Как в медицинских учреждениях воздействовать на пути передачи инфекций, вызванных возбудителями с высокой устойчивостью к антибиотикам, таких как ванкомицин-резистентный Enterococcus faecium (ВРЭ)? Перспективный подход основан на повышении сопротивляемости кишечника к колонизации путем введения защитных кишечных бактерий. У мышей бактериальный трансплантат, по-видимому, восстанавливает устойчивость к колонизации и уменьшает удельную массу ВРЭ в кишечнике. Это было достигнуто с помощью комбинации под названием «CBBPSCSK», состоящей из 4 бактериальных штаммов, включая Blautia producta (BPSCSK; где SCSK обозначает штамм Blautia). Тем не менее базовые механизмы еще предстоит выяснить. Частично эта задача была выполнена в работах, недавно опубликованных в журнале Nature американскими исследователями.
Лантибиотик, аналогичный консерванту E234
Результаты экспериментов показывают, что BPSCSK может помочь уменьшить рост ВРЭ путем выделения лантибиотика, аналогичного низину A, который вырабатывается Lactococcus lactis и широко используется в пищевой промышленности в качестве консерванта (E234). Аналогичный... но более эффективный и избирательный способ.
Более эффективный и избирательный in vivo
Хотя рост ВРЭ ингибируется как BPSCSK, так и L. lactis in vitro, все обстоит иначе in vivo: в толстой кишке обнаруживается только штамм BPSCSK (где он составляет около 25 % бактерий, имеющихся в течение 5 дней после введения CBBPSCSK); это снижает удельную массу ВРЭ и ингибирует грамположительные возбудители, сохраняя при этом другие кишечные комменсальные бактерии. Напротив, L. lactis не способен колонизировать желудочно-кишечный тракт и обладает более широким спектром действия за счет некоторых полезных бактерий.
Потенциальный пробиотический препарат
Результаты также особо указывают, что гены, кодирующие синтез лантибиотиков, присутствуют от природы в микробиоме человека у здоровых людей, а также что виды, продуцирующие лантибиотики, ингибируют ВРЭ. Кроме того, у 22 пациентов с высоким риском заражения инфекцией, обусловленной ВРЭ (поскольку они подвергались трансплантации гемопоэтических клеток), высокое содержание генов, кодирующих продуцирование лантибиотика, было связано со сниженной численностью E. faecium. Аналогично у безмикробных мышей, которым трансплантировали фекальные препараты от этих пациентов, устойчивость к колонизации ВРЭ коррелирует с большой распространенностью гена лантибиотика. Это подтверждает идею, что кишечные бактерии, продуцирующие лантибиотик, уменьшают колонизацию ВРЭ и являются потенциальными пробиотическими препаратами, которые могут восстанавливать сопротивляемость к колонизации этим болезнетворным микроорганизмом.
* Низкомолекулярный бактериальный пептид с антимикробным действием, продуцируемый большим количеством грамположительных бактерий.